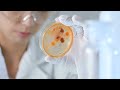

КАКОЙ САМЫЙ АГРЕССИВНЫЙ РАК МОЛОЧНОЙ ЖЕЛЕЗЫ
Самым агрессивным видом рака молочной железы является инвазивный дуктальный карцинома. Этот вид рака характеризуется способностью быстро распространяться из протоков молочной железы в окружающую ткань, а также имеет высокую вероятность образования метастазов в других органах.
Агрессивный РМЖ. Какой прогноз на выход в ремиссию?
Рак молочной железы 4 стадии. Опыт пациентки клиники \
Chapter 3: Правила определения стадии рака (Cancer Staging: Rules)
Елены Слободской,, 3 стадия рак молочной железы, трижды негативный. После лечения 2 инсульта
Самые агрессивные формы рака.
Виды рака молочной железы. Прогнозы и методы лечения
Почему не удалить опухоль сразу? - Рак молочной железы
РАК ГРУДИ l Как предотвратить? l Рак молочных желез
Рак молочной железы Часть 6. Тройной негативный подтип